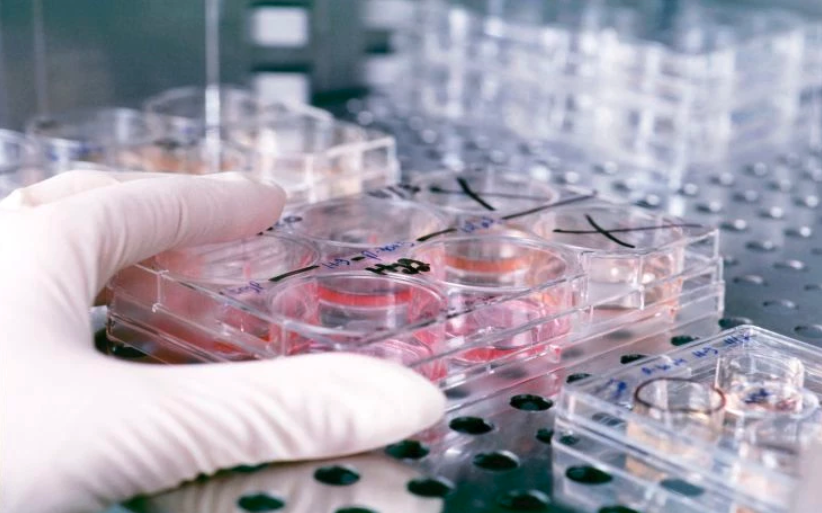

Προσπαθώντας για ένα μωρό: «Η εξωσωματική γίνεται μονομανία, θέλει φοβερές αντοχές για να μη σε καταπιεί η προσπάθεια»
Γυναίκες σε διαδικασία εξωσωματικής και μια διακεκριμένη γυναικολόγος μιλούν στο Newsbeast για την προσπάθεια της υποβοηθούμενης αναπαραγωγής και τα σκοτεινά σημεία της | Δήμητρα Τριανταφύλλου
ο 1987 γεννήθηκε το πρώτο στην Ελλάδα -και τρίτο στον κόσμο- μωρό με τη μέθοδο της εξωσωματικής γονιμοποίησης. Τότε μάλιστα ονομάστηκε «το πρώτο παιδί του σωλήνα», φράση που χρησιμοποιήθηκε για λίγα χρόνια ακόμα, μέχρι να εγκαταλειφθεί εντελώς αφού θεωρήθηκε στιγματιστική.
Ήδη από τότε, η χώρα μας σημείωνε μεγάλες επιτυχίες στην υποβοηθούμενη αναπαραγωγή. Μάλιστα, από το 2005 και με τη σύμφωνη γνώμη της νομοθεσίας, διαδικασίες υποβοηθούμενης αναπαραγωγής, που σε άλλες χώρες απαγορεύονταν -παρένθετη μητρότητα, δωρεά ωαρίων και εμβρύων σε ετερόφυλα ζευγάρια ή γυναίκες χωρίς σύντροφο- οδήγησαν στο να γίνει αυτό το κομμάτι ένα ισχυρό κομμάτι της συγκεκριμένης βιομηχανίας στην Ελλάδα.
Της οποίας βιομηχανίας ο τζίρος εκτιμάται ότι αγγίζει παγκοσμίως τουλάχιστον τα 10 δις ετησίως. Την ίδια στιγμή, σύμφωνα με την Παγκόσμια Οργάνωση Υγείας, υπογόνιμοι είναι 80.000.000 άνθρωποι ενώ 16%-26% του γυναικείου πληθυσμού στις αναπτυγμένες χώρες προσπαθούν να αποκτήσουν παιδιά με ιατρική παρέμβαση.
Μέσα σε όλο αυτό το πλαίσιο, οι γυναικολόγοι που ασχολούνται στην Ελλάδα με την υποβοηθούμενη αναπαραγωγή θεωρούνται συχνά από τις γυναίκες που προσπαθούν να μείνουν έγκυες κάτι σαν «μικροί θεοί». Αρκετές γυναίκες μετά από πολλές προσπάθειες και δαπάνη τεράστιων ποσών αρχίζουν να αισθάνονται ότι πέφτουν θύματα εκμετάλλευσης αυτής της βιομηχανίας και αρχίζουν να «αυτοοργανώνονται» και να ανταλλάσσουν βιώματα και πληροφορίες μέσα από διαδικτυακά φόρουμ συζήτησης για το συγκεκριμένο θέμα.
Η Κατερίνα Σβολίμη, 41 ετών, προσπαθεί να μείνει έγκυος με τη διαδικασία της εξωσωματικής εδώ και 17 μήνες. Ξεκινώντας να μας περιγράφει την περίπτωσή της λέει τα εξής: «Παντρεύτηκα στα 39 μου και ο σύζυγός μου ήταν τότε 43 ετών. Επειδή όμως εκείνος είναι ναυτικός η εγκυμοσύνη είναι εξ’ ορισμού δύσκολη. Όταν είδα ότι δεν ερχόταν με φυσικό τρόπο και με δεδομένη την ηλικία μου, αποφάσισα να προσπαθήσω με εξωσωματική. Γρήγορα κατάλαβα ότι όλη αυτή η διαδικασία θα απαιτούσε πολλά, πολλά χρήματα. Οι ενέσεις κοστίζουν από 300 ως 400 ευρώ η κάθε μια. Όλα τα χρήματα που έχω δαπανήσει μέχρι στιγμής, από το παραμικρό φάρμακο, μέχρι την κορτιζόνη, τις ενέσεις και την κάθε εξέταση της χοριακής (σ.σ η ορμόνη, η οποία παράγεται στο σώμα της γυναίκας κατά τη διάρκεια της κύησης και αυτή που ανιχνεύεται στα ούρα ή στο αίμα για να επιβεβαιωθεί μια εγκυμοσύνη) κοντεύουν τα 20.000 ευρώ. Υπάρχει υποτίθεται μια κρατική επιτροπή από την οποία μπορείς να περάσεις. Εκτός από την ατελείωτη γραφειοκρατία της, πολλά από τα έξοδα που θα χρειαστούν στην πορεία δεν καλύπτονται και γενικώς μέχρι να γίνει δεκτή η αίτηση σου, αν γίνει, έχεις ήδη χάσει ατελείωτο χρόνο. Δεν θέλησα να μπω σε αυτή τη διαδικασία. Άλλωστε, στην περίπτωση μας δεν υπάρχει σοβαρός ιατρικός λόγος που να συντρέχει, είναι απλά θέμα ηλικίας».

Η ίδια έχει επίγνωση αυτών των δεδομένων. Όπως μας λέει: «Είχα ήδη διαβάσει επιστημονικές έρευνες και γνώριζα πως τα ποσοστά μιας επιτυχημένης προσπάθειας όσο μεγαλώνει η ηλικία πέφτουν. Έχω μείνει όμως έγκυος στο παρελθόν, όταν ήμουν νεότερη. Σε κάθε περίπτωση, αν ένας γιατρός δεν θέλει να σε παραμυθιάσει θα σου μιλήσει έξω από τα δόντια για αυτό».
Στα μισά της διαδρομής και μετά από τέσσερις αποτυχημένες εμβρυομεταφορές η Κατερίνα άλλαξε γιατρό. «Ο πρώτος μού φάνηκε στυγνός εκμεταλλευτής. Μεγάλο όνομα, αλλά είχα καταλάβει ότι όσο περνούσε ο καιρός είχε αφήσει το αντικείμενο και τις εξελίξεις του και έμεινε να κυνηγάει το χρήμα.
Διαβάζοντας στα φόρουμ και τις ιστορίες άλλων γυναικών συνειδητοποίησα το εξής- πολλοί γιατροί δεν σε παραπέμπουν εξ ’αρχής στο να ψαχτείς συνολικά. Και το κάνουν αυτό γιατί ξέρουν ότι η εξωσωματική είναι ένα εμπόριο ελπίδας. Πολλοί, ξεκινούν να σε “ερευνούν” μετά από την τέταρτη αποτυχημένη προσπάθεια. Πολλές μα πάρα πολλές γυναίκες στα φόρουμ, αναφέρουν ότι συγκεκριμένα προβλήματα τους βρέθηκαν μετά από πολλές αποτυχημένες προσπάθειες.

Όσο για τη στήριξη που παίρνει από τον άντρα της η Κατερίνα λέει πως: «ευτυχώς, είναι μεγάλη. Μου έχει εμπιστοσύνη, ξέρει ότι δεν είμαι άνθρωπος ‘πρόβατο’ και με ακολουθεί. Και κάτι που κατάλαβα μέσα από αυτή την ιστορία είναι πως ακόμα και αν δεν τα καταφέρουμε, αφού έχουμε βάλει ένα όριο σε όλο αυτό, θα είμαστε καλά ανεξαρτήτως παιδιού».
Τα καλά και τα κακά των φόρουμ όπου συζητείται non stop το θέμα
Όπως και τα ιδιωτικά κέντρα υποβοηθούμενης αναπαραγωγής, τα οποία είναι δεκάδες σε όλη τη χώρα, έτσι και τα φόρουμ συζήτησης της υποβοηθούμενης αναπαραγωγής, εκεί όπου κάθε γυναίκα συζητά τη δική της μικρή ιστορία, είναι και αυτά πολλά και «συσπειρώνουν» πλήθος γυναικών με τα ποστ να «πέφτουν» με καταιγιστικούς ρυθμούς. Όπως λέει η Κατερίνα: «Είμαι μέλος σε αρκετά φόρουμ και βλέπω πολλά. Γυναίκες να συζητούν για τις βιταμίνες και τα σκευάσματα που πιστεύουν ότι θα τις βοηθήσουν. Βλέπεις συμβουλές για να τραβάς τα μαλλιά σου.
Βλέπω και πολλές γυναίκες που είναι επίμονες με την υποβοηθούμενη τεκνοποίηση πέραν του κανονικού. Ένας βασικός λόγος που τους συμβαίνει αυτό είναι γιατί ξέρουν ότι δεν έχουν μέλλον και στο κομμάτι της υιοθεσίας, το οποίο στην Ελλάδα είναι κάκιστο. Πολλές από αυτές δεν θα προσπαθούσαν τόσο αν ήξεραν ότι μπορούν να τα καταφέρουν με την υιοθεσία.
Κάποια στιγμή, όλη αυτή η προσπάθεια μέσω εξωσωματικής γίνεται μονομανία. Κόντεψα και εγώ κάποια στιγμή να τρελαθώ και τότε είπα στον εαυτό μου: “σταμάτα, δεν είσαι εσύ αυτή”.

Κάποιες φορές βλέπεις και ζήλια και ανταγωνισμό ανάμεσα στις γυναίκες που γράφουν για τα προβλήματά τους. Από ένα σημείο και έπειτα, η εξωσωματική γίνεται εθισμός. Ξυπνάς το πρωί και λατρεύεις το ότι έχεις ραντεβού με τον γυναικολόγο και αύριο με τον ενδοκρινολόγο και μεθαύριο με τον αιματολόγο. Σαν να έχεις φτιάξει ένα νέο σύμπαν ζωής. Η συνεχής προσπάθεια σε κατατρώει. Αν δεν έχεις ισχυρές αντιστάσεις, σε ρουφάει εντελώς.
Από την άλλη, μέσα σε αυτή τη συχνή παράνοια των φόρουμ, οι γυναίκες είναι βοηθητικές μεταξύ τους ενώ ανταλλάσσουν και πολύτιμες πληροφορίες. Μια που γνωρίζει έναν καλό ενδοκρινολόγο αναπαραγωγής θα τον συστήσει στις υπόλοιπες. Και τον καινούργιο γυναικολόγο που έχω τώρα και με τον οποίο είμαι πολύ ευχαριστημένη, σε φόρουμ τον βρήκα».
«Θέλω τουλάχιστον ο γιατρός να θυμάται το ιστορικό μου όταν με βλέπει»
Η Αγγελική Μπουσιούτα, 35 χρονών, ξεκίνησε να προσπαθεί να μείνει έγκυος με υποβοηθούμενη αναπαραγωγή πριν από δύο χρόνια. Μέχρι τότε, είχε ήδη προσπαθήσει με φυσικό τρόπο για αρκετά χρόνια.
Η Αγγελική, γνώρισε την Κατερίνα σε μια ιατρική αίθουσα ενός ιδιωτικού κέντρου υποβοηθούμενης αναπαραγωγής. Η Αγγελική θυμάται καλά αυτή τη στιγμή. «Ήμασταν και οι δύο στο κρεβάτι της ωοληψίας και οι δύο ναρκωμένες και μας χώριζε μια κουρτίνα. Τώρα, δεν υπάρχει μέρα που να μην επικοινωνήσουμε. Έχουμε αναπτύξει μια φοβερή σχέση γιατί, κακά τα ψέματα, ο άνθρωπος που βιώνει την ίδια διαδικασία με εσένα είναι ο μόνος που μπορεί να συναισθανθεί στο 100% τι περνάς».

Ξεκινώντας να περιγράφει τη δική της ιστορία, η Αγγελική λέει ότι είναι μαζί με τον σύζυγό της από όταν ήταν κι οι δύο 17 χρονών (ο άντρας της έχει την ίδια ηλικία με εκείνη). Όπως περιγράφει η ίδια: «Για αρκετά χρόνια προσπαθούσαμε με ηρεμία. Στη συνέχεια και δεδομένου ότι δεν βρέθηκε κάποιο πρόβλημα σε εμένα ή στον σύζυγο, ο γυναικολόγος που είχα τότε, ξεκίνησε τις προσπάθειες για εξωσωματική με χαμηλές δόσεις και όχι πολλές ορμόνες. Έκανα προσπάθεια κάθε δύο μήνες. Βγήκαν ωάρια για πέντε προσπάθειες με τη διαδικασία να συνεχίζεται».
Επί έναν ολόκληρο χρόνο ασχολούμουν με την εξωσωματική σαν ρομπότ, non stop. Κάπου εκεί και διαβάζοντας τις εμπειρίες άλλων γυναικών στα φόρουμ, έκανα ένα διάλειμμα γιατί κατάλαβα ότι για να μείνεις έγκυος δεν φτάνει ένας καλός γυναικολόγος, αλλά ότι έπρεπε να διερευνήσω και άλλα θέματα. Όπως και η Κατερίνα, έτσι και εγώ, δεν είδα να γίνονται αναλυτικές εξετάσεις πριν προχωρήσω. Δεν ήθελα ούτε εγώ να περάσω από δημόσια επιτροπή- ζητούν τόσες πολλές εξετάσεις που μέχρι να κλείσεις τα ραντεβού στο δημόσιο σύστημα υγείας έχεις χάσει πολύ χρόνο. Γραφειοκρατία και ψυχική ταλαιπωρία. Επιπρόσθετα, άνθρωποι σαν εμένα και τον άντρα όπου για το δικό μας πρόβλημα οι γιατροί έχουν καταλήξει στο “υπογόνιμο ζευγάρι για αδιευκρίνιστο λόγο” σχεδόν αποκλειόμαστε από αυτή τη διαδικασία.
Άλλαξα λοιπόν γιατρό αφού κατάλαβα ότι τα πολύ μεγάλα και φτασμένα ονόματα σε αντιμετωπίζουν σαν άλλο ένα νούμερο στις πολλές πελάτισσες τους. Εγώ έχω ανάγκη από μια μίνιμουμ ανθρώπινη ζεστασιά από τον γιατρό μου. Να θυμάται τουλάχιστον όποτε με βλέπει τη φαρμακευτική αγωγή μου και το ιστορικό μου. Είχαν ήδη υπάρξει φορές που έπαιρνα 17 χάπια την ημέρα και είχα πρηστεί φοβερά. Ο ενδοκρινολόγος που βρήκα μετά μου είπε ότι αυτή η δόση θα μπορούσε να είχε προκαλέσει υπερδιέγερση ορμονών. Στην αρχή της διαδικασίας όμως δεν μου μιλούσε κανείς για όλα αυτά».

Η Αγγελική εξηγεί και πως επηρεάζει ένα ζευγάρι αυτή η φορτωμένη με τόση ελπίδα και προσδοκίες και πολλές φορές και με τόση ματαίωση και απογοήτευση, διαδικασία. Όπως λέει η ίδια: «ξέρω αρκετά ζευγάρια που χώρισαν στη διαδρομή και κατηγόρησε ο ένας τον άλλο για το ποιανού ήταν το “λάθος”. Αυτή η διαδικασία είτε θα σε φέρει πιο κοντά, είτε θα σε χωρίσει. Εμείς, κάθε φορά που ξεκινάμε μια νέα προσπάθεια ερχόμαστε ακόμα πιο κοντά. Παίζει ρόλο και το ότι πριν ξεκινήσουμε κάναμε μια μεγάλη συζήτηση. Μιλήσαμε για όλα- τι deadline θα βάλουμε στις προσπάθειες και τι θα κάνουμε στο τέλος αν δεν μας συμβεί αυτό που θέλουμε. Είπαμε πως ακόμα και να φανεί στη διαδρομή πως ένας από τους δύο έχει το θέμα, το πρόβλημα θα είναι πάντα κοινό.

«Ζευγάρια συνεχίζουν την προσπάθεια χωρίς να δίνονται απαντήσεις»
Η Σοφία Καλανταρίδου, Καθηγήτρια Μαιευτικής, Γυναικολογίας και Στείρωσης του Εθνικού και Καποδιστριακού Πανεπιστημίου Αθηνών και Πρόεδρος της Εθνικής Αρχής Ιατρικώς Υποβοηθούμενης Αναπαραγωγής από το Νοέμβριο του 2018 έως τον Οκτώβριο του 2020 έχει αρκετά ενδιαφέροντα πράγματα να πει για το ζήτημα από ιατρικής απόψεως.
Κατ’ αρχάς, η ίδια εξηγεί πως στο 40% των περιπτώσεων η υπογονιμότητα οφείλεται σε γυναικείο παράγοντα, σε 40% σε ανδρικό και σε 20% και στους δύο. Όπως εξηγεί η κα Καλανταρίδου: «οι βασικές εξετάσεις στις οποίες πρέπει να υποβληθεί ένα ζευγάρι με υπογονιμότητα πριν προχωρήσει σε υποβοηθούμενη αναπαραγωγή ορίζονται από την κείμενη νομοθεσία. Βέβαια, οι εξελίξεις στην υποβοηθούμενη αναπαραγωγή είναι καταιγιστικές και οι διεθνείς κατευθυντήριες οδηγίες συνεχώς υπαγορεύουν περαιτέρω ενδελεχείς ελέγχους, ιδιαίτερα όταν έχουν προηγηθεί αποτυχημένες προσπάθειες τεκνοποίησης με υποβοηθούμενη αναπαραγωγή.
Μία μελέτη στις ΗΠΑ περισσοτέρων από μισό εκατομμύριο κύκλων εξωσωματικής γονιμοποίησης έδειξε ότι η πιθανότητα επίτευξης κύησης μετά την πρώτη προσπάθεια είναι 36%, μετά τη δεύτερη προσπάθεια 48% και μετά την τρίτη προσπάθεια 53%. Αν όμως ένα ζευγάρι δεν επιτύχει κύηση μετά από τρεις προσπάθειες εξωσωματικής γονιμοποίησης, μετά τα αποτελέσματα δεν είναι ιδιαίτερα ενθαρρυντικά. Η επιτυχία επίτευξης κύησης εξαρτάται κατά ένα μεγάλο ποσοστό από την ηλικία της γυναίκας. Η πιθανότητα επίτευξης κύησης σε κάθε εμμηνορρυσιακό κύκλο μιας γυναίκας 30 ετών είναι 20%, ενώ η πιθανότητα αυτή μιας γυναίκας 40 ετών είναι λιγότερο από 5% και μειώνεται ακόμη περισσότερο μετά την ηλικία των 45 ετών. Αυτά τα ποσοστά ισχύουν είτε πρόκειται για αυτόματη σύλληψη είτε για εξωσωματική γονιμοποίηση».
Σύμφωνα με τα στοιχεία που δημοσίευσε η Ευρωπαϊκή Εταιρεία Ανθρώπινης Αναπαραγωγής και Εμβρυολογίας (European Society of Human Reproduction and Embryology, ESHRE) το 2016 έγιναν στην Ελλάδα συνολικά 27.976 θεραπείες υποβοηθούμενης αναπαραγωγής σε 13.922 γυναίκες ηλικίας 15-45 ετών, εκ των οποίων οι 4.462 αφορούσαν κύκλους με δωρεά ωαρίων και οι 4.785 κύκλους με εμβρυομεταφορά κατεψυγμένων εμβρύων.

Να σημειωθεί εδώ πως σύμφωνα με την κα Καλανταρίδου, στην Ελλάδα, η παροχή υπηρεσιών ιατρικής υποβοήθησης της αναπαραγωγής είναι υψηλού επιπέδου, διασφαλίζοντας υπηρεσίες ασφαλείς, αξιόπιστες και με υψηλά ποσοστά επιτυχίας. Όπως λέει η ίδια: «Η χώρα μας αποτελεί πόλο έλξης πολιτών από πολλές χώρες του κόσμου που επιθυμούν να τεκνοποιήσουν με μεθόδους της ιατρικώς υποβοηθούμενης αναπαραγωγής».
Ως εδώ όλα καλά. Παρόλα αυτά, όπως τονίζει η έμπειρη γυναικολόγος: «στην Ελλάδα, υπάρχει δυστυχώς έλλειμμα πληροφόρησης των νέων ζευγαριών σε θέματα αναπαραγωγικής υγείας και υποβοηθούμενης αναπαραγωγής. Για παράδειγμα, πολλά ζευγάρια δεν γνωρίζουν ότι σε αρκετά δημόσια νοσοκομεία υπάρχουν Μονάδες Υποβοηθούμενης Αναπαραγωγής. Την έλλειψη πληροφόρησης την είδαμε να συμβαίνει πρόσφατα και με το ζήτημα του εμβολιασμού των εγκύων έναντι του κορωνοϊού SARS-CoV-2, με αποτέλεσμα το θάνατο ανεμβολίαστων εγκύων. Στις περισσότερες ευρωπαϊκές χώρες, οι πληροφορίες είναι αναλυτικές και εμφανείς σε έναν δημόσιο κεντρικό ιστότοπο, π.χ στη Βρετανία σημαντική πηγή πληροφόρησης είναι η Βρετανική Αρχή Υποβοηθούμενης Αναπαραγωγής (Human Fertilisation and Embryology Authority, HFEA, https://www.hfea.gov.uk/)».

Ένα άλλο πρόβλημα που εντοπίζει η κα Καλανταρίδου είναι πως μετά την τρίτη αποτυχημένη προσπάθεια θα πρέπει να γίνει περαιτέρω έλεγχος, πριν την επόμενη προσπάθεια υποβοηθούμενης αναπαραγωγής. Όπως όμως υπογραμμίζει η ίδια: «Δυστυχώς παρατηρείται το φαινόμενο να συνεχίζει ένα ζευγάρι τις προσπάθειες χωρίς να δοθούν απαντήσεις για τις προηγούμενες αποτυχημένες προσπάθειες. Βλέπουμε επίσης, για παράδειγμα, ζευγάρια που έχουν επανειλημμένες αποβολές να υποβάλλονται σε υποβοηθούμενη αναπαραγωγή, ενώ θα έπρεπε να υποβληθούν στον απαραίτητο κλινικο-εργαστηριακό έλεγχο και αντιμετώπιση, σύμφωνα με τις διεθνείς κατευθυντήριες οδηγίες.
Έχει τύχει αρκετές φορές, στα δημόσια νοσοκομεία να έρχονται ζευγάρια, μετά από πολλές αποτυχημένες προσπάθειες και σε προχωρημένη πια ηλικία για εγκυμοσύνη, ως μια τελευταία λύση και έχοντας ήδη ξοδέψει μια μικρή περιουσία στις προηγούμενες προσπάθειες τους. Γι’ αυτό και είναι σημαντική η ύπαρξη ψυχολόγου σε κάθε Μονάδα Υποβοηθούμενης Αναπαραγωγής, καθώς και η σωστή ενημέρωση του ζευγαριού ώστε να αποφασίζει πότε θα πρέπει να προχωρήσει σε νέα προσπάθεια επίτευξης κύησης ή να σταματήσει και να αναζητήσει άλλες λύσεις».







